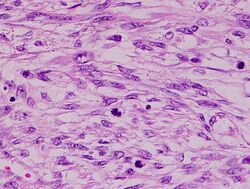

Leiomyosarcoma
 From Handwiki
From Handwiki | Leiomyosarcoma | |
|---|---|
| Other names | LMS |
 | |
| Leiomyosarcoma of the adrenal vein. Coronal view of abdominal MRI. Tumor (arrow) extends from the superior pole of the right kidney to the right atrium. | |
| Specialty | Hematology and Oncology |
A leiomyosarcoma, also known as LMS, is a rare malignant (cancerous) smooth muscle tumor.[1] The origin of the word is from leio- + myo- + sarcoma which means malignant smooth muscle tumor. The stomach, bladder, uterus, blood vessels, and intestines are examples of hollow organs made up of smooth muscles where LMS can be located, however the uterus or abdomen are the most common sites.[2]
Although leiomyosarcomas are rare, they belong to of the more common types of soft-tissue sarcoma, representing 10 to 20% of new cases.[2] This type of cancer is more frequently diagnosed in adults as compared to children.[2] Additionally, when considering LMS specifically in the context of the uterus, it affects approximately 6 individuals per 1 million people in the United States each year.[2] LMSs are resistant cancers, meaning they are generally not very responsive to chemotherapy or radiation. The best outcomes occur when the tumor tissue can be removed surgically at an early stage, while it is small and has not yet spread from the original site (it remains in situ).[3] LMSs are seen in adults more often than they are seen in children.[4]
Mechanism
Smooth muscle cells make up the involuntary muscles, which are found in most parts of the body, including the uterus, stomach and intestines, the walls of all blood vessels, and the skin. These are the areas where LMSs originate from.[5] LMSs also often develop in the retroperitoneal region[4] which consists of the suprarenal glands, the kidney, and ureter. Just as it is not known what truly causes most sarcomas, LMSs have similarly complex karyotypes and it is suggested that because of the complexity, genomic instability might be the cause.[4]
Uterine leiomyosarcomas come from the smooth muscle in the muscle layer of the uterus.[6] Cutaneous leiomyosarcomas derive from the pilo-erector muscles in the skin. Gastrointestinal leiomyosarcomas might come from smooth muscle in the GI tract, or alternatively, from a blood vessel. At most other primary sites—retroperitoneal extremity (in the abdomen, behind the intestines), truncal, abdominal organs, etc.—leiomyosarcomas appear to grow from the muscle layer of a blood vessel (the tunica media). Thus, a leiomyosarcoma can have a primary site of origin anywhere in the body from a blood vessel.[3]
The tumors are usually hemorrhagic and soft and microscopically marked by pleomorphism, abundant (15–30 per 10 high-power fields) abnormal mitotic figures, and coagulative tumor cell necrosis. The differential diagnosis, which includes spindle cell carcinoma, spindle cell melanoma, fibrosarcoma, malignant peripheral nerve sheath tumor and even biphenotypic sinonasal sarcoma, is wide.
Diagnosis

To diagnose LMS, a physical exam may be performed by one’s physician, imaging tests such as MIT, CT and PET scans can be performed, or tissue biopsies can also be completed where the histopathology of the removed tissue sample is examined.[1] Because LMS is a widespread disease, the symptoms vary based on the location of the tumor and also, the size.[2] Some of the symptoms include nausea and vomiting, palpable lumps, pain, bleeding and unintentional weight loss.[2]
Treatment
Surgery, with as wide a margin of removal as possible, has generally been the most effective and preferred way to attack LMS. If surgical margins are narrow or not clear of tumor, however, or in some situations where tumor cells were left behind, chemotherapy or radiation has been shown to give a clear survival benefit.[8] While LMS tends to be resistant to radiation and chemotherapy, each case is different and results can vary widely.
For metastatic (widespread) disease, chemotherapy and targeted therapies are the first choices. Chemotherapy regimens include: doxorubicin/ifosfamide and doxorubicin combination/gemcitabine and docetaxel/trabectedin;[9] pazopanib is the targeted therapy used in metastatic leiomyosarcoma as second line and is well tolerated.[10]
LMS of uterine origin often responds to hormonal treatments.[11][12] As of 2020, several clinical trials for uterine LMS are active.[13]
Uterine leiomyomas vs uterine leiomyosarcomas
Leiomyomas are benign smooth muscle tumors that have overlapping features with leiomyosarcomas. Although both originate from smooth muscle, it is important to note that leiomyomas do not mature to become leiomyosarcomas.[14] Leiomyomas are seen in pre-menopausal women and are symptomatic 20-50% of the time, while leiomyosarcomas, the most common uterine sarcomas, are seen in older post-menopausal women[15] with 40-60 being the peak age incidence.[16] Since leiomyomas are benign and mostly asymptomatic, minimally invasive treatment modalities are used to treat them.[15] For this same reason, it is crucial to distinguish them from LMSs before surgical procedures to ensure that laparoscopic procedures or diagnosis delay will not lead to heightened morbidity given the poor prognosis of LMS.[15] For example, the FDA has warned against using morcellation for benign leiomyomas as those with unsuspected sarcomas are at risk of cancer spread.[17]
Notable cases
People who have had leiomyosarcoma include:
- Leicester City footballer Keith Weller, who made over 300 appearances for the Foxes, scored 47 goals. Also, he made four appearances for England, scoring one goal.[18]
- Katie Price[19]
- Canadian public-health physician Sheela Basrur (1956–2008) developed uterine leiomyosarcoma in 2006.[20]
- American actress Diana Sands[21]
- The first year of treatment for leiomyosarcoma of Canadian comedian Irwin Barker was the subject of a 2008 television documentary, That's My Time; he died in 2010.[22]
- E. J. McGuire, long-time professional ice hockey coach, scout, and vice president of the National Hockey League Central Scouting Bureau[citation needed]
- Ellis Avery, American writer, two-time winner of the Stonewall Book Award[citation needed]
- Linda Uttley (1966–2009), English rugby union footballer in the Women's England Team, was diagnosed with leiomyosarcoma in 2007 and died in 2009 at the age of 43.[23]
- Irene Hirano Inouye, founding President of the U.S.-Japan Council, a position she held ever since she helped create the organization in 2009.
See also
- Uterine sarcoma
References
- ↑ 1.0 1.1 "Leiomyosarcoma - Overview - Mayo Clinic". https://www.mayoclinic.org/diseases-conditions/leiomyosarcoma/cdc-20387733.
- ↑ 2.0 2.1 2.2 2.3 2.4 2.5 "Leiomyosarcoma - NCI" (in en). 2020-06-22. https://www.cancer.gov/pediatric-adult-rare-tumor/rare-tumors/rare-soft-tissue-tumors/leiomyosarcoma.
- ↑ 3.0 3.1 "Basic info". http://www.leiomyosarcoma.info/basic.htm.
- ↑ 4.0 4.1 4.2 Kumar, Vinay; Abbas, Abul K.; Aster, Jon C. (2021). "Chapter 26: Bones, Joints, and Soft Tissue Tumors" (in English). Robbins & Cotran Pathologic Basis of Disease (10th ed.). Jeremy Bowes. pp. 1208. ISBN 978-0-323-53113-9.
- ↑ Kumar, Vinay; Abbas, Abul K.; Aster, Jon C. (2021). "Chapter 26: Bones, Joints, and Soft Tissue Tumors". Robbins & Cotran Pathologic Basis of Disease (10th ed.). Jeremy Bowes. p.1213. ISBN 978-0-323-53113-9.
- ↑ "Leiomyosarcoma of the Uterus (ULMS): A Review". The Liddy Shriver Sarcoma Initiative. 2007. http://sarcomahelp.org/learning_center/leiomyosarcoma_uterus.html.
- ↑ Vijay Shankar, M.D.. "Soft tissue - Smooth muscle - Leiomyosarcoma - general". http://www.pathologyoutlines.com/topic/softtissueleiomyosarcoma.html. Topic Completed: 1 November 2012. Revised: 11 September 2019
- ↑ "About Chemotherapy". August 2002. http://www.leiomyosarcoma.info/chemo10therapy.htm.
- ↑ Rastogi, Sameer; Bakhshi, Sameer (2016). "Trabectedin in Soft Tissue Sarcoma: Have We Hit the Bull's-eye?". Journal of Clinical Oncology 34 (29): 3582–3583. doi:10.1200/jco.2015.65.7130. PMID 27458287.
- ↑ Rastogi, Sameer; Sharma, Aparna; Vanidassane, Ilavarasi; Aggarwal, Aditi; Mridha, Asitranjan; Pandey, Rambha; Dhamija, Ekta; Barwad, Adarsh (2019). "Pazopanib efficacy and toxicity in a metastatic sarcoma cohort: Are Indian patients different?". Indian Journal of Cancer 56 (3): 207–210. doi:10.4103/ijc.IJC_105_18. PMID 31389382.
- ↑ Abu-Rustum, N. R.; Curtin, J. P.; Burt, M.; Jones, W. B. (1997). "Regression of uterine low-grade smooth-muscle tumors metastatic to the lung after oophorectomy". Obstetrics and Gynecology 89 (5 Pt 2): 850–852. doi:10.1016/S0029-7844(97)00033-1. PMID 9166348.
- ↑ Hardman, M. P.; Roman, J. J.; Burnett, A. F.; Santin, A. D. (2007). "Metastatic Uterine Leiomyosarcoma Regression Using an Aromatase Inhibitor". Obstetrics & Gynecology 110 (2 Pt 2): 518–520. doi:10.1097/01.AOG.0000267533.56546.c2. PMID 17666649.
- ↑ "Uterine Sarcoma Clinical Trials". https://www.cancer.gov/about-cancer/treatment/clinical-trials/disease/uterine-sarcoma.
- ↑ Kumar, Vinay; Abbas, Abul K.; Aster, Jon C. (2021). "Chapter 26: Bones, Joints, and Soft Tissue Tumors". Robbins & Cotran Pathologic Basis of Disease (10th ed.). Jeremy Bowes. p.1014.ISBN 978-0-323-53113-9.
- ↑ 15.0 15.1 15.2 Sun, S.; Bonaffini, P. A.; Nougaret, S.; Fournier, L.; Dohan, A.; Chong, J.; Smith, J.; Addley, H. et al. (October 2019). "How to differentiate uterine leiomyosarcoma from leiomyoma with imaging". Diagnostic and Interventional Imaging 100 (10): 619–634. doi:10.1016/j.diii.2019.07.007. ISSN 2211-5684. PMID 31427216. https://pubmed.ncbi.nlm.nih.gov/31427216/.
- ↑ Kumar, Vinay; Abbas, Abul K.; Aster, Jon C. (2021). "Chapter 26: Bones, Joints, and Soft Tissue Tumors". Robbins & Cotran Pathologic Basis of Disease (10th ed.). Jeremy Bowes. p.1015.ISBN 978-0-323-53113-9.
- ↑ Health, Center for Devices and Radiological (2020-12-30). "UPDATE: Perform Only Contained Morcellation When Laparoscopic Power Morcellation Is Appropriate: FDA Safety Communication" (in en). FDA. https://www.fda.gov/medical-devices/safety-communications/update-perform-only-contained-morcellation-when-laparoscopic-power-morcellation-appropriate-fda.
- ↑ "Leicester legend Weller mourned". BBC Online. 2004-11-13. http://news.bbc.co.uk/sport1/hi/football/teams/l/leicester_city/4009295.stm.
- ↑ "Jordan treated for cancer". BBC Online. 2002-08-11. http://news.bbc.co.uk/1/hi/uk/2185943.stm.
- ↑ Gillespie, Kerry (2008-04-12). "'Can't ever give up hope,' Basrur says". The Toronto Star. https://www.thestar.com/News/Canada/article/413828.
- ↑ Brown, Stacia. "Diana Sands: What Was and What Could've Been". http://www.clutchmagonline.com/2012/08/diana-sands-what-was-and-what-couldve-been/.
- ↑ "That's My Time". http://www.irwinbarker.com/thats_my_time.shtml. "In Irwin's own words: 'Cancer has my body but not my spirit, and I'll continue to make jokes, not so much about cancer, but in spite of it.'"
- ↑ Fiona Hackett (2009-11-27). "Former player Linda Uttley". https://www.waspsfc.co.uk/news/former-player-linda-uttley-81922.html. Retrieved 2022-02-28.
External links
- Gastrointestinal Stromal Tumors at eMedicine
| Classification | D
|
|---|---|
| External resources |
|
Template:Breast cancer/urogenital neoplasia
 |
Categories: [Rare cancers]
↧ Download as ZWI file | Last modified: 04/01/2024 16:28:36 | 1 views
☰ Source: https://handwiki.org/wiki/Medicine:Leiomyosarcoma | License: CC BY-SA 3.0

 KSF
KSF